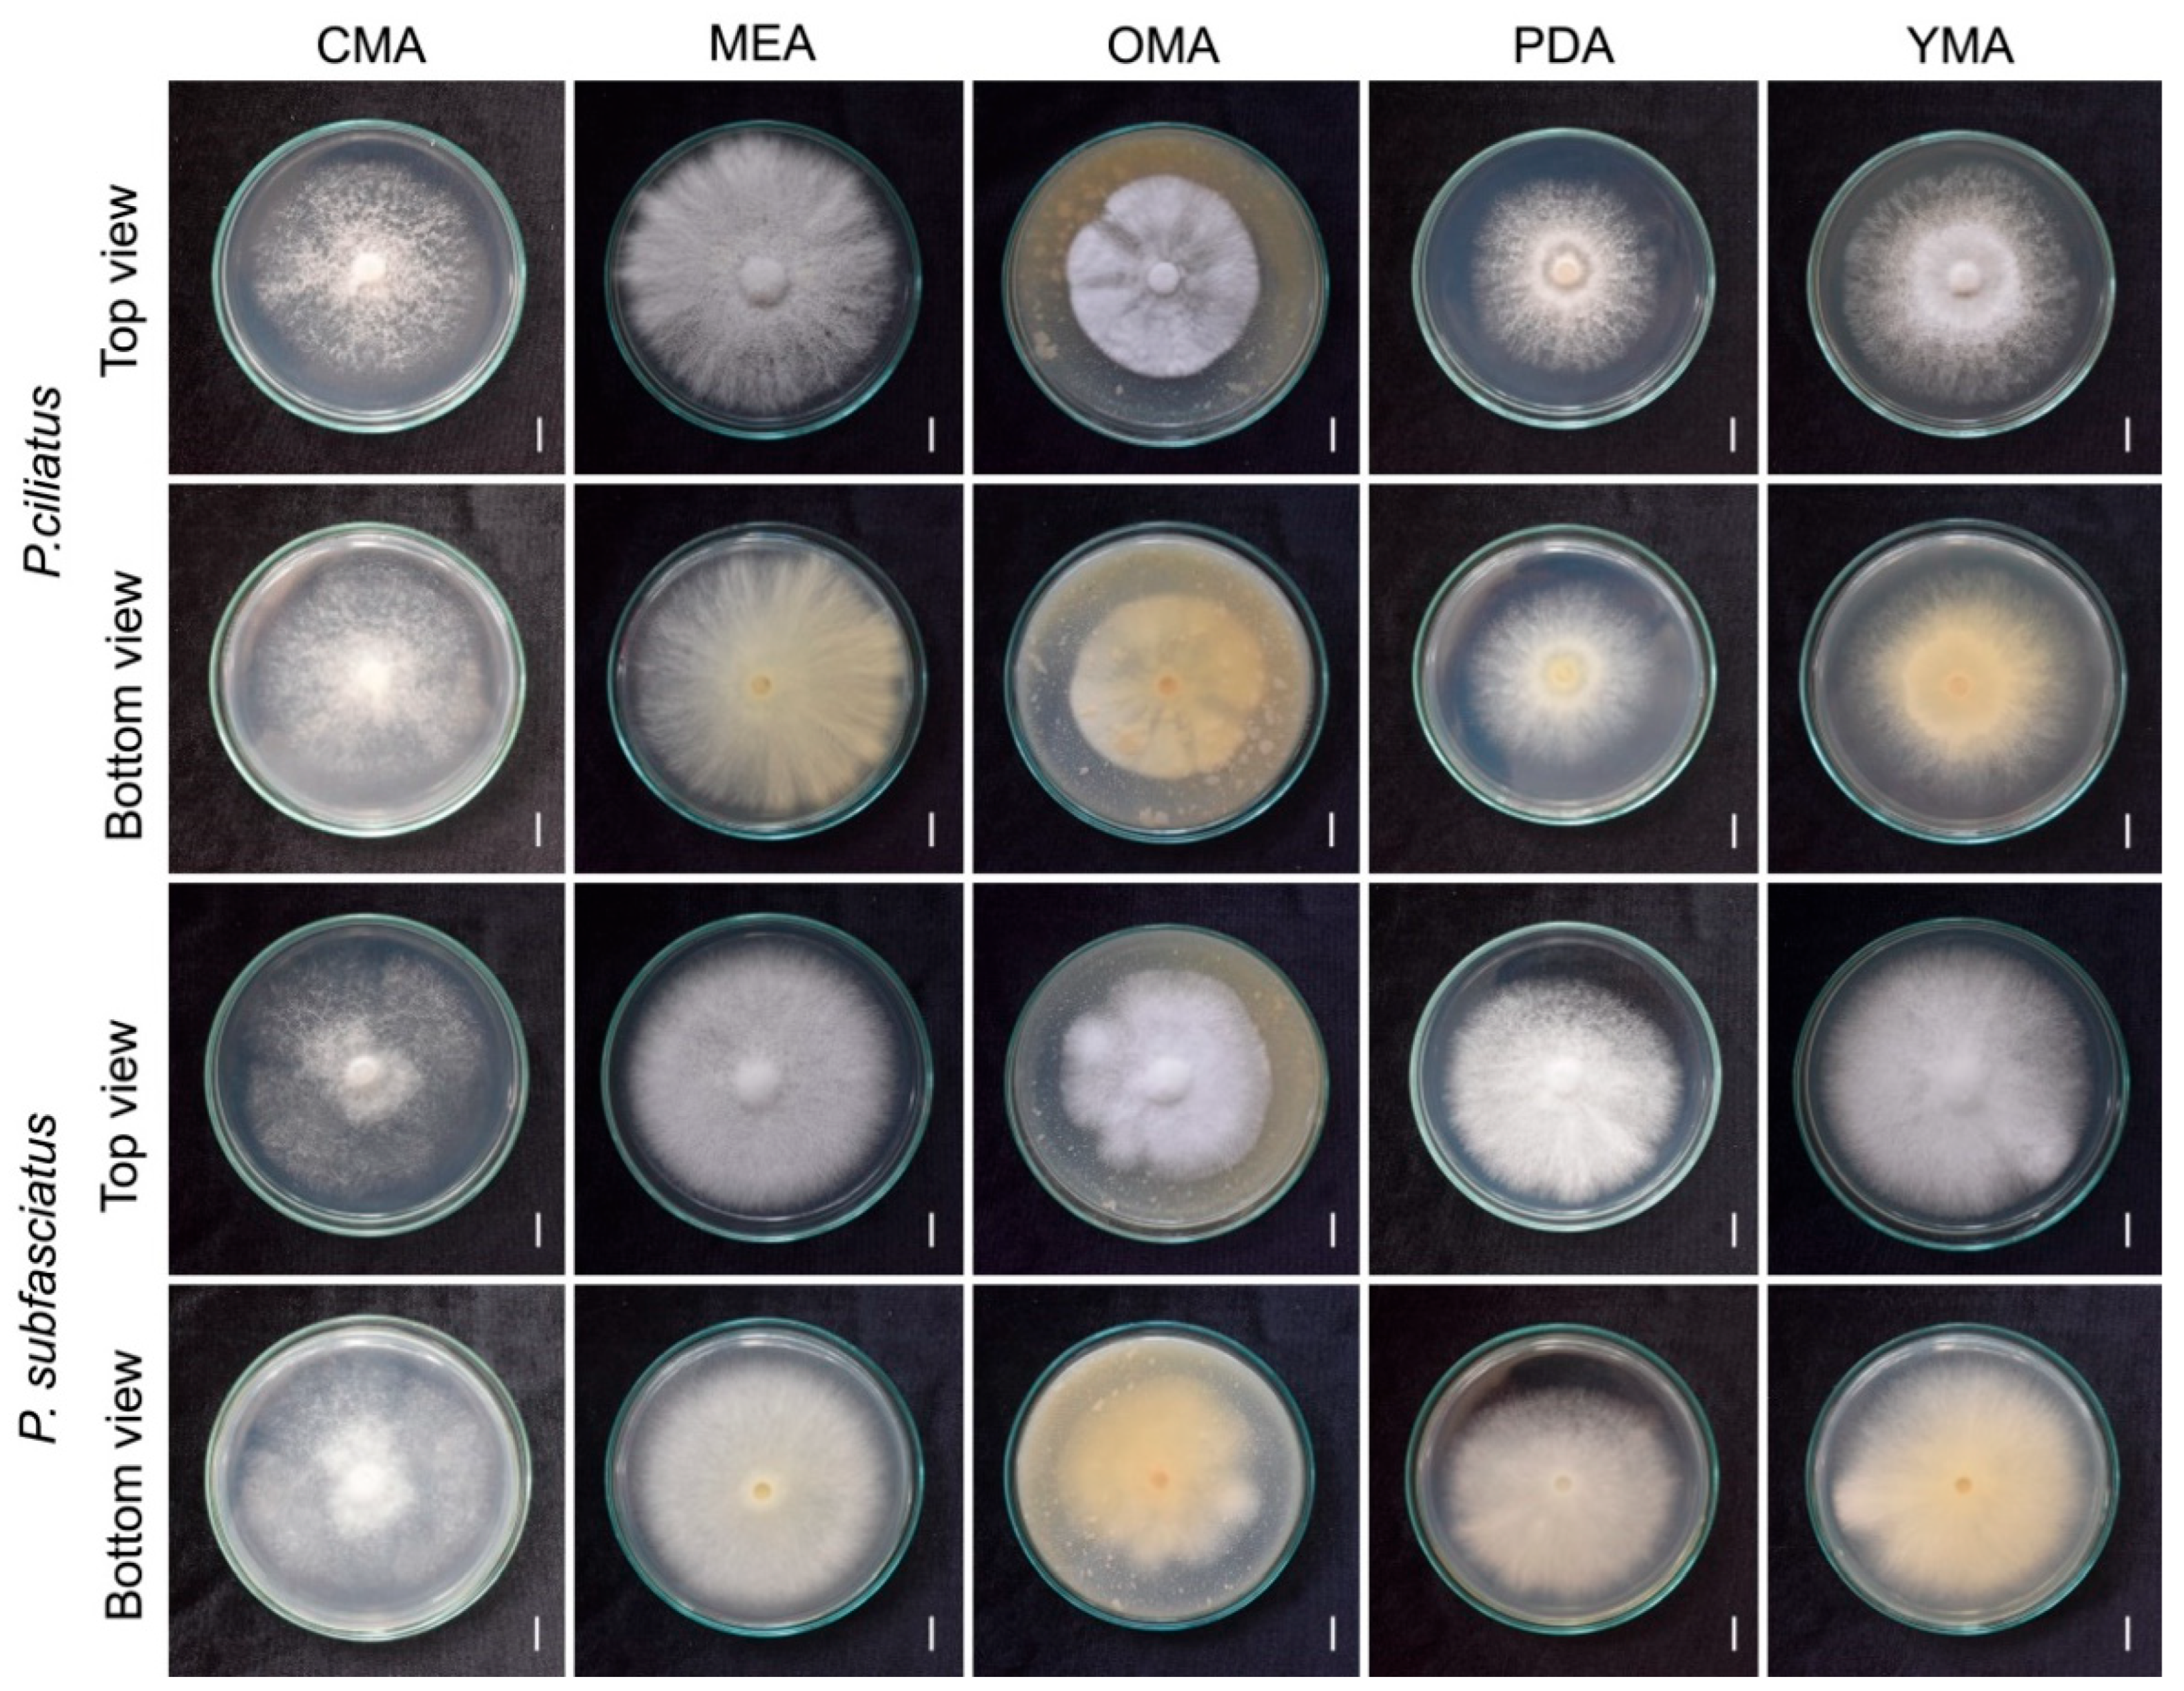
Jof 11 00826 g008

A Comprehensive Characterisation of Mycelium-Based Biomaterials Developed from Panus ciliatus and P. subfasciatus (Panaceae, Polyporales)
Abstract
1. Introduction
2. Materials and Methods
2.1. Specimen Collection and Isolation
2.2. Macro- and Micro-Morphological Descriptions
2.3. DNA Extraction, PCR Amplification, and DNA Sequencing
2.4. Sequence Alignments and Phylogenetic Analyses
| Fungal Species | Voucher | Geographic Origin/Country | GenBank Accession No. (ITS) | References |
|---|---|---|---|---|
| Panus baishanzuensis | FJAU67793.1 | China | PP273986 | [36] |
| P. baishanzuensis | FJAU67793 | China | PP273985 | [36] |
| P. bambusinus Type | AK61b | India | MW453097 | [2] |
| P. cf. tephroleucus | VOG36 | Brazil | MT669124 | [3] |
| P. ciliatus | MFLUCC 25-0173 | Thailand | PV393836 | This study |
| P. ciliatus | SP446150 | Brazil | MT669118 | [36] |
| P. conchatus | KUMCC18 0047 | China | MK192053 | [37] |
| P. conchatus | CLZhao 1452 | China | MG231758 | [3] |
| P. conchatus | Inat36307978 | USA | OM349507 | [3] |
| P. conchatus | LE265028 | Russia | KM411463 | [38] |
| P. conchatus | CBS 267.58 | Germany | MH857778 | [3] |
| P. conchatus | UOC-MINNP-M13 | Sri Lanka | KP776992 | [3] |
| P. conchatus | JZ30 | India | MG719287 | [3] |
| P. conchatus | A52 | Philippines | OM102535 | [3] |
| P. conchatus | UOC:SIGWI:S24 | Sri Lanka | KR818817 | [3] |
| P. fulvus | DS1687 | Brazil | MT669122 | [36] |
| P. lecomtei | HHB 9614 | USA | KP135329 | [39] |
| P. lecomtei | HHB-11042-Sp | USA | KP135328 | [39] |
| P. minisporus | FJAU67792 | China | PP273980 | [36] |
| P. minisporus | FJAU67792.1 | China | PP273981 | [36] |
| P. neostrigosus | LSPQ NSM 106 | Canada | KU761234 | [40] |
| P. neostrigosus | LSPQ NSM 107 | Canada | KU761235 | [40] |
| P. parvus | URM80840 | Brazil | MT669125 | [36] |
| P. purpuratus | PDD 96130 | New Zealand | MK404671 | [2] |
| P. roseus | HKAS 94714 | China | KY490136 | [2] |
| P. rudis | ZJ1005DKJ02 | China | KU863049 | [37] |
| P. rudis | ZJ1005DKJ03 | China | KU863050 | [37] |
| P. similis | LE287548 | Vietnam | KM411466 | [38] |
| P. similis | FJAU67794 | China | PP273984 | [36] |
| P. sribuabanensis | SDBR-CMUNK0930 | Thailand | OR447475 | [2] |
| P. sribuabanensis | SDBR-CMUNK0924 | Thailand | OR447474 | [2] |
| P. strigellus | B6 | Paraguay | MW407012 | [2] |
| P. subfasciatus Type | MFLU 16 2129 | Thailand | LT614958 | [41] |
| P. tephroleucus | CMINPA 1860 | Brazil | MN602052 | [3] |
| P. velutinus | CM10 | Brazil | MT669138 | [3] |
| P. velutinus | VOG30 | Brazil | MT669139 | [36] |
| P. strigellus | INPA222827 | Brazil | JQ955722 | [3] |
| P. subfasciatus | MFLUCC 25-0172 | Thailand | PV393835 | This study |
| Panus sp. | TAC2130a MO506033 | USA | OR336204 | GenBank |
| Panus sp. | G028 | China | KJ195662 | [3] |
| Cymatoderma elegans (outgroup) | Dai 17511 | China | ON417155 | [2] |
| Cymatoderma elegans (outgroup) | CBS 491.76 | Japan | JN649340 | [2] |
2.5. Evaluation of Culture Media for Optimal Mycelial Growth
2.6. Evaluation of Mycelial Growth in Lignocellulose Substrates
2.7. Preparation of Test Samples
2.7.1. Preparation of Spawn
2.7.2. Preparation of Mycelium Substrate Bags
2.7.3. Preparation of Mould
2.7.4. Fabrication of Mycelium-Based Biomaterials
2.7.5. Denaturation
2.8. Evaluation of Mycelium-Based Biomaterial Test Samples
2.8.1. Physical Properties
Moisture Content and Dry Density
Volumetric Shrinkage
2.8.2. Mechanical Properties
Compression Strength
Flexural Strength
Tensile Strength
Impact Strength
2.8.3. Hydrodynamic Properties
Water Absorption
Water Contact Angle
2.8.4. Chemical Properties
2.8.5. Scanning Electron Microscopy (SEM)
2.8.6. Thermogravimetric Analysis (TGA)
2.8.7. Fourier Transform Infrared Spectroscopy (FTIR)
2.8.8. Flammability
2.8.9. Soil Burial Degradability
2.9. Product Fabrication
2.10. Viability Maintenance of the Mushroom Strain
2.11. Data Collection and Statistical Analysis
3. Results
3.1. Taxonomy
- Panus ciliatus (Lév.) T.W. May & A.E. Wood, Figure 5
- ≡ Lentinus ciliatus Lév. Annls Sci. Nat., Bot., sér. 3 2: 175 (1844)
- Panus subfasciatus Thongbai, Karun., C. Richter & K.D. Hyde, Figure 6
3.2. Phylogenetic Inferences
3.3. Effect of Culture Media on Mycelial Growth
3.4. Mycelium Growth in Lignocellulose Substrate Media
3.5. Mycelium-Based Biomaterial Characterisation
3.5.1. Physical Properties
Moisture Content and Dry Density
Volumetric Shrinkage
3.5.2. Mechanical Properties
Compression Strength
Flexural Strength
Tensile Strength
Impact Strength
3.5.3. Hydrodynamic Properties
Water Absorption
Water Contact Angle
3.5.4. Chemical Properties
3.5.5. Scanning Electron Microscopy
3.5.6. Thermogravimetric Analysis (TGA)
3.5.7. Fourier Transform Infrared Spectroscopy
3.5.8. Flammability Test
3.5.9. Soil Burial Degradability
3.6. Developing Prototypes
3.7. Viability Maintenance of Mushroom Strains
4. Discussion
5. Challenges and Practical Recommendations
6. Conclusions
Author Contributions
Funding
Institutional Review Board Statement
Informed Consent Statement
Data Availability Statement
Acknowledgments
Conflicts of Interest
References
- Fries, E.M. Epicrisis Systematis Mycologici seu Synopsis Hymenomycetum; Typographia Academica Sumtibus Auctoris: Uppsala, Sweden, 1838. [Google Scholar]
- Kumla, J.; Jatuwong, K.; Tanruean, K.; Khuna, S.; Srinuanpan, S.; Lumyong, S.; Suwannarach, N. A new edible wild mushroom species, Panus sribuabanensis (Panaceae, Polyporales) from Northern Thailand and its nutritional composition, total phenolic content, and antioxidant activity. Mycobiology 2024, 52, 1–12. [Google Scholar] [CrossRef]
- Sousa-Guimarães, D.K.; Alves-Silva, G.; Bittencourt, F.; Camacho, O.; Menolli, N., Jr.; Góes-Neto, A.; Robledo, G.L.; Drechsler-Santos, E.R. A comprehensive phylogeny of Panus (Panaceae, Polyporales) and revisited Brazilian diversity. Mycol. Prog. 2024, 23, 19. [Google Scholar] [CrossRef]
- Corner, E. The agaric genera Lentinus, Panus and Pleurotus with particular reference to Malaysian species. Nova Hedwig. 1981, 69, 1–169. [Google Scholar]
- Pegler, D.N. Lentinus Fr. and related genera from Congo-Kinshasa (Fungi). Bull. Jard. Bot. Natl. Belg. 1971, 41, 273. [Google Scholar] [CrossRef]
- Pegler, D. The genus Lentinus: A world monograph. Kew Bull. Add. Ser. 1983, 10, 1–281. [Google Scholar]
- Vinjusha, N.; Arun Kumar, T. Two new combinations in the genus Panus (Panaceae, Polyporales) based on morphology and molecular phylogeny. Phytotaxa 2021, 514, 287–294. [Google Scholar] [CrossRef]
- Liu, S.; Zhou, J.L.; Song, J.; Sun, Y.F.; Dai, Y.C.; Cui, B.K. Climacocystaceae fam. nov. and Gloeoporellaceae fam. nov., two new families of Polyporales (Basidiomycota). Front. Microbiol. 2023, 14, 1115761. [Google Scholar] [CrossRef]
- He, M.Q.; Zhao, R.L.; Hyde, K.D.; Begerow, D.; Kemler, M.; Yurkov, A.; McKenzie, E.H.C.; Raspé, O.; Kakishima, M.; Sánchez-Ramírez, S.; et al. Notes, outline and divergence times of Basidiomycota. Fungal Divers. 2019, 99, 105–367. [Google Scholar] [CrossRef]
- Wijayawardene, N.; Hyde, K.D.; Dai, D.; Sánchez-García, M.; Goto, B.; Saxena, R.; Erdoğdu, M.; Selçuk, F.; Rajeshkumar, K.; Aptroot, A.; et al. Outline of fungi and fungus-like taxa—2021. Mycosphere 2022, 13, 53–453. [Google Scholar] [CrossRef]
- Vasco-Palacios, A.M.; Suaza, S.C.; Castanõ-Betancur, M.; Franco-Molano, A.E. Conocimiento etnoecólogico de los hongos entre los indígenas Uitoto, Muinane y Andoke de la Amazonía Colombiana. Acta Amaz. 2008, 38, 17–30. [Google Scholar] [CrossRef]
- Vargas-Isla, R.; Capelari, M.; Menolli, N.; Nagasawa, E.; Tokimoto, K.; Ishikawa, N.K. Relationship between Panus lecomtei and P. strigellus inferred from their morphological, molecular and biological characteristics. Mycoscience 2015, 56, 561–571. [Google Scholar] [CrossRef]
- Sharma, V.P.; Barh, A.; Kumari, B.; Annepu, S.K.; Sharma, S.; Kamal, S. Nutritional and biochemical characterization of Panus lecomtei mushroom (Agaricomycetes) from India and its cultivation. Int. J. Med. Mushrooms 2020, 22, 501–507. [Google Scholar] [CrossRef]
- Niego, A.G.; Rapior, S.; Thongklang, N.; Raspé, O.; Jaidee, W.; Lumyong, S.; Hyde, K.D. Macrofungi as a nutraceutical source: Promising bioactive compounds and market value. J. Fungi 2021, 7, 397. [Google Scholar] [CrossRef]
- Holt, G.A.; McIntyre, G.; Flagg, D.; Bayer, E.; Wanjura, J.D.; Pelletier, M.G. Fungal mycelium and cotton plant materials in the manufacture of biodegradable molded packaging material: Evaluation study of select blends of cotton byproducts. J. Biobased Mater. Bioenergy 2012, 6, 431–439. [Google Scholar] [CrossRef]
- Khyaju, S.; Luangharn, T. Diverse use of mushroom mycelium-based as biomaterial products: A mini review. Fungal Biotec. 2024, 4, 56–67. [Google Scholar] [CrossRef]
- Abhijith, R.; Ashok, A.; Rejeesh, C.R. Sustainable packaging applications from mycelium to substitute polystyrene: A review. Mater. Today Proc. 2018, 5, 2139–2145. [Google Scholar] [CrossRef]
- Fairus, M.J.M.; Bahrin, E.K.; Arbaain, E.N.N.; Ramli, N. Mycelium-based composite: A way forward for renewable material. J. Sustain. Sci. Manag. 2022, 17, 271–280. [Google Scholar] [CrossRef]
- Aiduang, W.; Chanthaluck, A.; Kumla, J.; Jatuwong, K.; Srinuanpan, S.; Waroonkun, T.; Oranratmanee, R.; Lumyong, S.; Suwannarach, N. Amazing fungi for eco-friendly composite materials: A comprehensive review. J. Fungi 2022, 8, 842. [Google Scholar] [CrossRef] [PubMed]
- Raman, J.; Kim, D.-S.; Kim, H.-S.; Oh, D.-S.; Shin, H.-J. Mycofabrication of mycelium-based leather from brown-rot fungi. J. Fungi 2022, 8, 317. [Google Scholar] [CrossRef]
- Khyaju, S.; Salichanh, T.; Khongphinitbunjong, K.; Duangphet, S.; Hyde, K.D.; Luangharn, T. Phlebiopsis friesii (Phanerochaetaceae, Polyporales), a new record in Thailand and the first preliminary characterization of its potential in mycelium mats. Mycobiology 2025, 53, 480–494. [Google Scholar] [CrossRef]
- Sydor, M.; Cofta, G.; Doczekalska, B.; Bonenberg, A. Fungi in mycelium-based composites: Usage and recommendations. Materials 2022, 15, 6283. [Google Scholar] [CrossRef]
- Hibbett, D.S.; Murakami, S.; Tsuneda, A. Sporocarp ontogeny in Panus (Basidiomycotina): Evolution and classification. Am. J. Bot. 1993, 80, 1336–1348. [Google Scholar] [CrossRef]
- Lodge, D.J.; Ammirati, J.F.; O’Dell, T.E.; Mueller, G.M. Collecting and Describing Macrofungi. Biodiversity of Fungi: Inventory and Monitoring Methods; Elsevier Academic Press: Amsterdam, The Netherlands, 2004; pp. 128–158. ISBN 0-12-509551-1. [Google Scholar]
- Kornerup, A.; Wansher, J. Methuen Handbook of Colour, 3rd ed.; Politikens Forlag: Copenhagen, Denmark, 1967; pp. 1–243. ISBN 0-413-33400-7. [Google Scholar]
- White, T.J.; Bruns, T.; Lee, S.; Taylor, J. Amplification and direct sequencing of fungal ribosomal RNA genes for phylogenetics. In PCR Protocols; Elsevier: Amsterdam, The Netherlands, 1990; pp. 315–322. ISBN 978-0-12-372180-8. [Google Scholar]
- Hall, T.A. BioEdit: A user-friendly biological sequence alignment editor and analysis program for Windows 95/98/NT. In Nucleic Acids Symposium Series; Oxford University Press: Oxford, UK, 1999; pp. 95–98. [Google Scholar]
- Kearse, M.; Moir, R.; Wilson, A.; Stones-Havas, S.; Cheung, M.; Sturrock, S.; Buxton, S.; Cooper, A.; Markowitz, S.; Duran, C.; et al. Geneious Basic: An integrated and extendable desktop software platform for the organization and analysis of sequence data. Bioinformatics 2012, 28, 1647–1649. [Google Scholar] [CrossRef]
- Katoh, K.; Rozewicki, J.; Yamada, K.D. MAFFT online service: Multiple sequence alignment, interactive sequence choice and visualization. Brief. Bioinform. 2019, 20, 1160–1166. [Google Scholar] [CrossRef]
- Capella-Gutiérrez, S.; Silla-Martínez, J.M.; Gabaldón, T. TrimAl: A tool for automated alignment trimming in large-scale phylogenetic analyses. Bioinformatics 2009, 25, 1972–1973. [Google Scholar] [CrossRef]
- Talavera, G.; Castresana, J. Improvement of phylogenies after removing divergent and ambiguously aligned blocks from protein sequence alignments. Syst. Biol. 2007, 56, 564–577. [Google Scholar] [CrossRef]
- Edler, D.; Klein, J.; Antonelli, A.; Silvestro, D. raxmlGUI 2.0: A graphical interface and toolkit for phylogenetic analyses using RAxML. Methods Ecol. Evol. 2021, 12, 373–377. [Google Scholar] [CrossRef]
- Ronquist, F.; Teslenko, M.; Van Der Mark, P.; Ayres, D.L.; Darling, A.; Höhna, S.; Larget, B.; Liu, L.; Suchard, M.A.; Huelsenbeck, J.P. MrBayes 3.2: Efficient Bayesian phylogenetic inference and model choice across a large model space. Syst. Biol. 2012, 61, 539–542. [Google Scholar] [CrossRef] [PubMed]
- Rambaut, A.; Drummond, A.J.; Xie, D.; Baele, G.; Suchard, M.A. Posterior summarization in Bayesian phylogenetics using Tracer 1.7. Syst. Biol. 2018, 67, 901–904. [Google Scholar] [CrossRef]
- He, M.-Q.; Cao, B.; Liu, F.; Boekhout, T.; Denchev, T.T.; Schoutteten, N.; Denchev, C.M.; Kemler, M.; Gorjón, S.P.; Begerow, D.; et al. Phylogenomics, divergence times and notes of orders in Basidiomycota. Fungal Divers. 2024, 126, 127–406. [Google Scholar] [CrossRef]
- Yue, L.; Chen, J.; Tuo, Y.; Qi, Z.; Liu, Y.; He, X.L.; Zhang, B.; Hu, J.; Li, Y. Taxonomy and phylogeny of Panus (Polyporales, Panaceae) in China and its relationship with allies. MycoKeys 2024, 105, 267–294. [Google Scholar] [CrossRef]
- Luangharn, T.; Karunarathna, S.C.; Mortimer, P.E.; Hyde, K.D.; Thongklang, N.; Xu, J. A new record of Ganoderma tropicum (Basidiomycota, Polyporales) for Thailand and first assessment of optimum conditions for mycelia production. MycoKeys 2019, 51, 65–83. [Google Scholar] [CrossRef]
- Zmitrovich, I.V.; Kovalenko, A.E. Lentinoid and polyporoid fungi, two generic conglomerates containing important medicinal mushrooms in molecular perspective. Int. J. Med. Mushrooms 2016, 18, 23–38. [Google Scholar] [CrossRef]
- Floudas, D.; Hibbett, D.S. Revisiting the taxonomy of Phanerochaete (Polyporales, Basidiomycota) using a four gene dataset and extensive ITS sampling. Fungal Biol. 2015, 119, 679–719. [Google Scholar] [CrossRef]
- Dufresne, P.J.; Moonjely, S.S.; Ozaki, K.; Tremblay, C.; Laverdière, M.; Dufresne, S.F. High frequency of pathogenic Aspergillus species among nonsporulating moulds from respiratory tract samples. Med. Mycol. 2017, 55, 233–236. [Google Scholar] [CrossRef] [PubMed]
- Tibpromma, S.; Hyde, K.D.; Jeewon, R.; Maharachchikumbura, S.S.N.; Liu, J.-K.; Bhat, D.J.; Jones, E.B.G.; McKenzie, E.H.C.; Camporesi, E.; Bulgakov, T.S.; et al. Fungal diversity notes 491–602: Taxonomic and phylogenetic contributions to fungal taxa. Fungal Divers. 2017, 83, 1–261. [Google Scholar] [CrossRef]
- Luangharn, T. Morphological and molecular identification of Panus conchatus (Polyporaceae, Polyporales) from Yunnan Province, China. Stud. Fungi 2019, 4, 253–262. [Google Scholar] [CrossRef]
- Luangharn, T. Antibacterial activity, optimal culture conditions and cultivation of the medicinal Ganoderma australe, new to Thailand. Mycosphere 2017, 8, 1108–1123. [Google Scholar] [CrossRef]
- Özdemir, E.; Saeidi, N.; Javadian, A.; Rossi, A.; Nolte, N.; Ren, S.; Dwan, A.; Acosta, I.; Hebel, D.E.; Wurm, J.; et al. Wood-veneer-reinforced mycelium composites for sustainable building components. Biomimetics 2022, 7, 39. [Google Scholar] [CrossRef]
- Aiduang, W.; Kumla, J.; Srinuanpan, S.; Thamjaree, W.; Lumyong, S.; Suwannarach, N. Mechanical, physical, and chemical properties of mycelium-based composites produced from various lignocellulosic residues and fungal species. J. Fungi 2022, 8, 1125. [Google Scholar] [CrossRef]
- Ly, L.; Jitjak, W. Biocomposites from agricultural wastes and mycelia of a local mushroom, Lentinus squarrosulus (Mont.) Singer. Open Agric. 2022, 7, 634–643. [Google Scholar] [CrossRef]
- Elsacker, E.; Vandelook, S.; Brancart, J.; Peeters, E.; De Laet, L. Mechanical, physical and chemical characterisation of mycelium-based composites with different types of lignocellulosic substrates. PLoS ONE 2019, 14, e0213954. [Google Scholar] [CrossRef]
- Appels, F.V.W.; Camere, S.; Montalti, M.; Karana, E.; Jansen, K.M.B.; Dijksterhuis, J.; Krijgsheld, P.; Wösten, H.A.B. Fabrication factors influencing mechanical, moisture- and water-related properties of mycelium-based composites. Mater. Des. 2019, 161, 64–71. [Google Scholar] [CrossRef]
- Attias, N.; Danai, O.; Tarazi, E.; Pereman, I.; Grobman, Y.J. Implementing bio-design tools to develop mycelium-based products. Des. J. 2019, 22, 1647–1657. [Google Scholar] [CrossRef]
- Antinori, M.E.; Contardi, M.; Suarato, G.; Armirotti, A.; Bertorelli, R.; Mancini, G.; Debellis, D.; Athanassiou, A. Advanced mycelium materials as potential self-growing biomedical scaffolds. Sci. Rep. 2021, 11, 12630. [Google Scholar] [CrossRef]
- Alemu, D.; Tafesse, M.; Mondal, A.K. Mycelium-based composite: The future sustainable biomaterial. Int. J. Biomater. 2022, 2022, 8401528. [Google Scholar] [CrossRef] [PubMed]
- Sánchez, Ó.J.; Montoya, S. Assessment of polysaccharide and biomass production from three white-rot fungi by solid-state fermentation using wood and agro-industrial residues: A kinetic approach. Forests 2020, 11, 1055. [Google Scholar] [CrossRef]
- Attias, N.; Danai, O.; Ezov, N.; Tarazi, E.; Grobman, Y.J. Developing novel applications of mycelium-based bio-composite materials for design and architecture. In Proceedings of the Building with Bio-Based Materials: Best Practice and Performance Specification, Final COST Action FP1303 International Scientific Conference, Zagreb, Croatia, 6–7 September 2017. [Google Scholar]
- Cartabia, M.; Girometta, C.E.; Milanese, C.; Baiguera, R.M.; Buratti, S.; Branciforti, D.S.; Vadivel, D.; Girella, A.; Babbini, S.; Savino, E.; et al. Collection and characterization of wood decay fungal strains for developing pure mycelium mats. J. Fungi 2021, 7, 1008. [Google Scholar] [CrossRef] [PubMed]
- Suthatho, A.; Rattanawongkun, P.; Tawichai, N.; Tanpichai, S.; Boonmahitthisud, A.; Soykeabkaew, N. Low-density all-cellulose composites made from cotton textile waste with promising thermal insulation and acoustic absorption properties. ACS Appl. Polym. Mater. 2024, 6, 390–397. [Google Scholar] [CrossRef]
- Aiduang, W.; Jatuwong, K.; Jinanukul, P.; Suwannarach, N.; Kumla, J.; Thamjaree, W.; Teeraphantuvat, T.; Waroonkun, T.; Oranratmanee, R.; Lumyong, S. Sustainable innovation: Fabrication and characterization of mycelium-based green composites for modern interior materials using agro-industrial wastes and different species of fungi. Polymers 2024, 16, 550. [Google Scholar] [CrossRef]
- Léveillé, J. Champignons exotiques. Ann. Sci. Nat. Bot. 1844, 3e, 167–221. [Google Scholar]
- Haneef, M.; Ceseracciu, L.; Canale, C.; Bayer, I.S.; Heredia-Guerrero, J.A.; Athanassiou, A. Advanced materials from fungal mycelium: Fabrication and tuning of physical properties. Sci. Rep. 2017, 7, 41292. [Google Scholar] [CrossRef]
- Pandey, K.K.; Pitman, A.J. FTIR studies of the changes in wood chemistry following decay by brown-rot and white-rot fungi. Int. Biodeterior. Biodegrad. 2003, 52, 151–160. [Google Scholar] [CrossRef]
- Schwanninger, M.; Rodrigues, J.C.; Pereira, H.; Hinterstoisser, B. Effects of short-time vibratory ball milling on the shape of FT-IR spectra of wood and cellulose. Vibr. Spectrosc. 2004, 36, 23–40. [Google Scholar] [CrossRef]
- D’Souza, R.A.; Kamat, N.M. Potential of FTIR spectroscopy in chemical characterization of Termitomyces pellets. J. Appl. Biol. Biotechnol. 2017, 5, 80–84. [Google Scholar] [CrossRef]
- Akcay, C.; Ceylan, F.; Arslan, R. Production of oyster mushroom (Pleurotus ostreatus) from some waste lignocellulosic materials and FTIR characterization of structural changes. Sci. Rep. 2023, 13, 12897. [Google Scholar] [CrossRef] [PubMed]
- Naumann, A. A novel procedure for strain classification of fungal mycelium by cluster and artificial neural network analysis of Fourier transform infrared (FTIR) spectra. Analyst 2009, 134, 1215. [Google Scholar] [CrossRef]
- Girometta, C.; Picco, A.M.; Baiguera, R.M.; Dondi, D.; Babbini, S.; Cartabia, M.; Pellegrini, M.; Savino, E. Physico-mechanical and thermodynamic properties of mycelium-based biocomposites: A review. Sustainability 2019, 11, 281. [Google Scholar] [CrossRef]
- Jones, M.; Mautner, A.; Luenco, S.; Bismarck, A.; John, S. Engineered mycelium composite construction materials from fungal biorefineries: A critical review. Mater. Des. 2020, 187, 108397. [Google Scholar] [CrossRef]
- Manan, S.; Ullah, M.W.; Ul-Islam, M.; Atta, O.M.; Yang, G. Synthesis and applications of fungal mycelium-based advanced functional materials. J. Bioresour. Bioprod. 2021, 6, 1–10. [Google Scholar] [CrossRef]
- Yang, Z.; Zhang, F.; Still, B.; White, M.; Amstislavski, P. Physical and mechanical properties of fungal mycelium-based biofoam. J. Mater. Civ. Eng. 2017, 29, 04017030. [Google Scholar] [CrossRef]
- Teixeira, J.L.; Matos, M.P.; Nascimento, B.L.; Griza, S.; Holanda, F.S.R.; Marino, R.H. Production and mechanical evaluation of biodegradable composites by white rot fungi. Ciênc. Agrotec. 2018, 42, 676–684. [Google Scholar] [CrossRef]
- De Lima, G.G.; Schoenherr, Z.C.P.; Magalhães, W.L.E.; Tavares, L.B.B.; Helm, C.V. Enzymatic activities and analysis of a mycelium-based composite formation using peach palm (Bactris gasipaes) residues on Lentinula edodes. Bioresour. Bioprocess. 2020, 7, 58. [Google Scholar] [CrossRef]
- Robertson, O.; Høgdal, F.; Mckay, L.; Lenau, T. Fungal future: A review of mycelium biocomposites as an ecological alternative insulation material. In Proceedings of the Balancing Innovation and Operation, Lyngby, Denmark, 11–14 August 2020; The Design Society. Kgs.: Glasgow, UK, 2020. [Google Scholar]
- Jia, N.; Kagan, V.A. Mechanical performance of polyamides with influence of moisture and temperature—accurate evaluation and better understanding. In Plastics Failure Analysis and Prevention; Elsevier: Amsterdam, The Netherlands, 2001; pp. 95–104. ISBN 978-1-884207-92-1. [Google Scholar]
- Alexandre, H.; Blanchet, S.; Charpentier, C. Identification of a 49-kDa hydrophobic cell wall mannoprotein present in velum yeast which may be implicated in velum formation. FEMS Microbiol. Lett. 2000, 185, 147–150. [Google Scholar] [CrossRef] [PubMed]
- Feofilova, E. The fungal cell wall: Modern concepts of its composition and biological function. Microbiology 2010, 79, 711–720. [Google Scholar] [CrossRef]
- Hwang, S.G.; Li, Y.Y.; Lin, H.L. The use of sawdust mixed with ground branches pruned from wax apple or Indian jujube as substrate for cultivation of king oyster mushroom (Pleurotus eryngii). Horts 2015, 50, 1230–1233. [Google Scholar] [CrossRef]
- Kumla, J.; Suwannarach, N.; Sujarit, K.; Penkhrue, W.; Kakumyan, P.; Jatuwong, K.; Vadthanarat, S.; Lumyong, S. Cultivation of mushrooms and their lignocellulolytic enzyme production through the utilization of agro-industrial waste. Molecules 2020, 25, 2811. [Google Scholar] [CrossRef]
- Zimele, Z.; Irbe, I.; Grinins, J.; Bikovens, O.; Verovkins, A.; Bajare, D. Novel mycelium-based biocomposites (MBB) as building materials. J. Renew. Mater. 2020, 8, 1067–1076. [Google Scholar] [CrossRef]
- Joseph, P.V.; Joseph, K.; Thomas, S.; Pillai, C.K.S.; Prasad, V.S.; Groeninckx, G.; Sarkissova, M. The thermal and crystallisation studies of short sisal fibre reinforced polypropylene composites. Compos. Part A Appl. Sci. Manuf. 2003, 34, 253–266. [Google Scholar] [CrossRef]
- Bruscato, C.; Malvessi, E.; Brandalise, R.N.; Camassola, M. High performance of macrofungi in the production of mycelium-based biofoams using sawdust—sustainable technology for waste reduction. J. Clean. Prod. 2019, 234, 225–232. [Google Scholar] [CrossRef]
- Ahmadi, H.; O’Keefe, A.; Bilek, M.A.; Korehei, R.; Sella Kapu, N.; Martinez, M.D.; Olson, J.A. Investigation of properties and applications of cellulose-mycelium foam. J. Mater. Sci. 2022, 57, 10167–10178. [Google Scholar] [CrossRef]
- Jones, M.; Bhat, T.; Kandare, E.; Thomas, A.; Joseph, P.; Dekiwadia, C.; Yuen, R.; John, S.; Ma, J.; Wang, C.H. Thermal degradation and fire properties of fungal mycelium and mycelium-biomass composite materials. Sci. Rep. 2018, 8, 17583. [Google Scholar] [CrossRef] [PubMed]
- Zhang, X.; Fan, X.; Han, C.; Li, Y.; Price, E.; Wnek, G.; Liao, Y.T.T.; Yu, X. (Bill) Novel strategies to grow natural fibers with improved thermal stability and fire resistance. J. Clean. Prod. 2021, 320, 128729. [Google Scholar] [CrossRef]
- Tanpichai, S.; Witayakran, S. All-cellulose composites from pineapple leaf microfibers: Structural, thermal, and mechanical properties. Polym. Compos. 2018, 39, 895–903. [Google Scholar] [CrossRef]
- Tanpichai, S.; Phoothong, F.; Boonmahitthisud, A. Superabsorbent cellulose-based hydrogels cross-linked with borax. Sci. Rep. 2022, 12, 8920. [Google Scholar] [CrossRef]
- Alongi, J.; Carletto, R.A.; Bosco, F.; Carosio, F.; Di Blasio, A.; Cuttica, F.; Antonucci, V.; Giordano, M.; Malucelli, G. Caseins and hydrophobins as novel green flame retardants for cotton fabrics. Polym. Degrad. Stab. 2014, 99, 111–117. [Google Scholar] [CrossRef]
- Van Wylick, A.; Elsacker, E.; Yap, L.L.; Peeters, E.; De Laet, L. Mycelium composites and their biodegradability: An exploration on the disintegration of mycelium-based materials in soil. Constr. Technol. Archit. 2022, 1, 652–659. [Google Scholar] [CrossRef]
- Madusanka, C.; Udayanga, D.; Nilmini, R.; Rajapaksha, S.; Hewawasam, C.; Manamgoda, D.; Vasco-Correa, J. A review of recent advances in fungal mycelium based composites. Discov. Mater. 2024, 4, 13. [Google Scholar] [CrossRef]
- Salichanh, T.; Khyaju, S.; Luangharn, T. Short review of the potential and beneficial use of Ganoderma derived in medicinal, cultivation, and biomaterial applications. Curr. Res. Environ. Appl. Mycol. (J. Fungal Biol.) 2025, 15, 56–76. [Google Scholar] [CrossRef]
- Yin, J.; Xin, X.; Weng, Y.; Gui, Z. Transcriptome-wide analysis reveals the progress of Cordyceps militaris sub-culture degeneration. PLoS ONE 2017, 12, e0186279. [Google Scholar] [CrossRef]
- Chen, X.; Zhang, Z.; Liu, X.; Cui, B.; Miao, W.; Cheng, W.; Zhao, F. Characteristics analysis reveals the progress of Volvariella volvacea mycelium subculture degeneration. Front. Microbiol. 2019, 10, 2045. [Google Scholar] [CrossRef] [PubMed]
- Zhao, F.; Liu, X.; Chen, C.; Cheng, Z.; Wang, W.; Yun, J. Successive mycelial subculturing decreased lignocellulase activity and increased ROS accumulation in Volvariella volvacea. Front. Microbiol. 2022, 13, 997485. [Google Scholar] [CrossRef] [PubMed]

| Culture Agar Media | Mycelium Growth Rate (mm Day−1) | Mycelium Density | ||
|---|---|---|---|---|
| P. ciliatus | P. subfasciatus | P. ciliatus | P. subfasciatus | |
| CMA | 7.07 ± 0.14 b | 7.77 ± 0.13 b | 2+ | 2+ |
| MEA | 8.24 ± 0.61 a | 8.08 ± 0.14 a | 4+ | 4+ |
| OMA | 5.55 ± 0.12 d | 6.26 ± 0.14 c | 3+ | 3+ |
| PDA | 6.45 ± 0.06 c | 7.70 ± 0.34 b | 2+ | 3+ |
| YMA | 7.15 ± 0.28 b | 8.07 ± 0.20 a | 3+ | 4+ |
| Parameter | P. ciliates (MFLUCC 25-0173) | P. subfasciatus (MFLUCC 25-0172) | ||
|---|---|---|---|---|
| 95% Confidence Interval | Average | 95% Confidence Interval | Average | |
| Moisture content (%) | 54.38, 55.63 | 55 ± 0.51 | 53.61, 54.67 | 54.14 ± 0.43 |
| Dry density (kg/m3) | 267.48, 278.51 | 272.99 ± 4.44 | 267.41, 279.50 | 273.45 ± 4.87 |
| Volumetric shrinkage (%) | 7.60, 9.49 | 8.54 ± 0.76 | 6.88, 10.22 | 8.55 ± 1.35 |
| Parameter | P. ciliatus (MFLUCC 25-0173) | P. subfasciatus (MFLUCC 25-0172) | ||
|---|---|---|---|---|
| 95% Confidence Interval | Average | 95% Confidence Interval | Average | |
| Compressive strength (kPa) | 377.55, 446.46 | 412 ± 27.75 a | 479.96, 728.04 | 604 ± 99.90 b |
| Flexural strength (kPa) | 1113.90, 1538.10 | 1326 ± 170.82 a | 737.30, 862.70 | 800 ± 50.50 b |
| Tensile strength (kPa) | 859.34, 1117.95 | 988.65 ± 104.14 | – | – |
| Impact strength (kJ/m2) | 0.08, 0.17 | 0.13 ± 0.04 a | 0.06, 0.12 | 0.09 ± 0.03 a |
| Wave Number Range (cm−1) | Spectra | Peak (cm−1) | References | |
|---|---|---|---|---|
| P. ciliatus | P. subfasciatus | |||
| 3600–3000 | O−H stretching hydrogen bonds | 3281 | 3282 | [47,58] |
| 3000–2840 | C–H stretching in methyl and methylene groups | 2922 | 2921 | [47,59,60] |
| 2940–2840 | CH2 asymmetric stretching | 2853 | − | [47] |
| 2900–2850 | CH3 and CH2 stretching | 2853 | – | [61] |
| 1658–1625 | Amide I; chitin | 1640 | 1633 | [61] |
| 1560–1520 | C=C stretching of aromatic ring (syringyl) in lignin | 1547 | − | [47] |
| 1460–1400 | CH2 and CH3 deformation in the lignin and hemicellulose; CH2 in-plane bending vibrations in the cellulose and lignin | 1405 | − | [62] |
| 1370–1365 | Aliphatic C–H stretch in CH3 | 1370 | 1370 | [60] |
| 1375–1315 | O–H bending polysaccharide; Amide III | − | 1313 | [61] |
| 1250–1025 | C–O bond; β (1 → 3) glucan; cell wall polysaccharide | 1241, 1075 | 1248 | [61] |
| 1205–1200 | OH plane deformation in cellulose; C−C stretching, C–O stretching, C−H deformation | − | 1202 | [58,60] |
| 1162–1125 | C–O–C asymmetric valence vibration | 1146 | 1145 | [59,60] |
| 1060–1015 | C–O valence vibration from C3–O3H | 1031 | 1039 | [60] |
| 1047–1004 | Calky–O ether vibrations | 1028 | 1036 | [60] |
| 1185–900 | Polysaccharides | 992 | − | [63] |
| 950–700 | Glycosidic bond β–(1 → 4) arabinogalactans, galactomannans, and cellulose | 933, 943 | − | [62] |
Disclaimer/Publisher’s Note: The statements, opinions and data contained in all publications are solely those of the individual author(s) and contributor(s) and not of MDPI and/or the editor(s). MDPI and/or the editor(s) disclaim responsibility for any injury to people or property resulting from any ideas, methods, instructions or products referred to in the content. |
© 2025 by the authors. Licensee MDPI, Basel, Switzerland. This article is an open access article distributed under the terms and conditions of the Creative Commons Attribution (CC BY) license (https://creativecommons.org/licenses/by/4.0/).
Share and Cite
Khyaju, S.; Hyde, K.D.; Khongphinitbunjong, K.; Duangphet, S.; Aiduang, W.; Luangharn, T. A Comprehensive Characterisation of Mycelium-Based Biomaterials Developed from Panus ciliatus and P. subfasciatus (Panaceae, Polyporales). J. Fungi 2025, 11, 826. https://doi.org/10.3390/jof11120826
Khyaju S, Hyde KD, Khongphinitbunjong K, Duangphet S, Aiduang W, Luangharn T. A Comprehensive Characterisation of Mycelium-Based Biomaterials Developed from Panus ciliatus and P. subfasciatus (Panaceae, Polyporales). Journal of Fungi. 2025; 11(12):826. https://doi.org/10.3390/jof11120826
Chicago/Turabian StyleKhyaju, Sabin, Kevin D. Hyde, Kitiphong Khongphinitbunjong, Sitthi Duangphet, Worawoot Aiduang, and Thatsanee Luangharn. 2025. "A Comprehensive Characterisation of Mycelium-Based Biomaterials Developed from Panus ciliatus and P. subfasciatus (Panaceae, Polyporales)" Journal of Fungi 11, no. 12: 826. https://doi.org/10.3390/jof11120826
APA StyleKhyaju, S., Hyde, K. D., Khongphinitbunjong, K., Duangphet, S., Aiduang, W., & Luangharn, T. (2025). A Comprehensive Characterisation of Mycelium-Based Biomaterials Developed from Panus ciliatus and P. subfasciatus (Panaceae, Polyporales). Journal of Fungi, 11(12), 826. https://doi.org/10.3390/jof11120826

